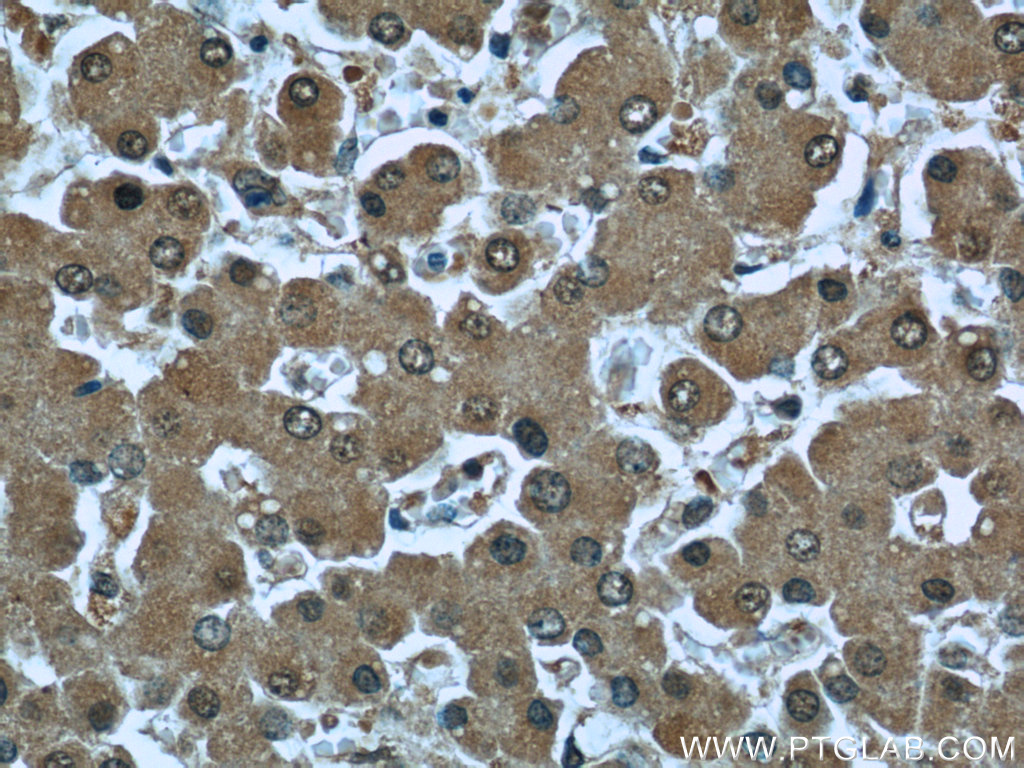

验证数据展示
产品信息
66104-1-PBS targets RBP4 in WB, IHC, IF/ICC, IF-P, ELISA applications and shows reactivity with human samples.
| 经测试应用 | WB, IHC, IF/ICC, IF-P, ELISA Application Description |
| 经测试反应性 | human |
| 免疫原 |
CatNo: Ag19295 Product name: Recombinant human RBP4 protein Source: e coli.-derived, PET28a Tag: 6*His Domain: 1-201 aa of BC020633 Sequence: MKWVWALFLLAALGSGRAERDCRVSSFRVKENFDKARFSGTWYAMAKKDPEGLFLQDNIVAEFSVDETGQMSATAKGRVRLLNNWDVCADMVGTFTDTEDPAKFKMKYWGVASFLQKGNDDHWIVDTDYDTYAVQYSCRLLNLDGTCADSYSFVFSRDPNGLPPEAQKIVRQRQEELCLARQYRLIVHNGYCDGRSERNLL 种属同源性预测 |
| 宿主/亚型 | Mouse / IgG2a |
| 抗体类别 | Monoclonal |
| 产品类型 | Antibody |
| 全称 | retinol binding protein 4, plasma |
| 别名 | 1D12B11, Plasma retinol binding protein, Plasma retinol-binding protein, Plasma retinol-binding protein(1-176), Plasma retinol-binding protein(1-179) |
| 计算分子量 | 201 aa, 23 kDa |
| 观测分子量 | 23 kDa |
| GenBank蛋白编号 | BC020633 |
| 基因名称 | RBP4 |
| Gene ID (NCBI) | 5950 |
| RRID | AB_2881503 |
| 偶联类型 | Unconjugated |
| 形式 | Liquid |
| 纯化方式 | Protein A purification |
| UNIPROT ID | P02753 |
| 储存缓冲液 | PBS only, pH 7.3. |
| 储存条件 | Store at -80°C. The product is shipped with ice packs. Upon receipt, store it immediately at -80°C |
背景介绍
RBP4 (retinol-binding protein 4) is a carrier protein that transports vitamin A (retinol) from the liver to the peripheral tissues. Synthesized primarily by hepatocytes and adipocytes as a 21 kDa non-glycosylated protein, RBP4 is secreted into the circulation as a retinol-RBP4 complex. In plasma the RBP4-retinol complex is bound to transthyretin (TRR), which prevents prevent kidney filtration. Two truncated forms of RBP4, RBP4-L (truncated at Leu-183) and RBP4-LL (truncated at Leu-182 and Leu-183), exist by proteolytic process. RBP4-L and RBP4-LL, which do not bind TTR, are normally excreted into the urine but accumulate in the serum during renal failure. Urinary RBP4 has been reported as marker for glomerular disease. RBP4 also was identified as an adipokine that elevated in some INS-resistant states. Measurement of serum RBP4 could be used to assess the risk of INS resistance, type 2 diabetes, obesity, and cardiovascular disease. (18752671, 16034410)